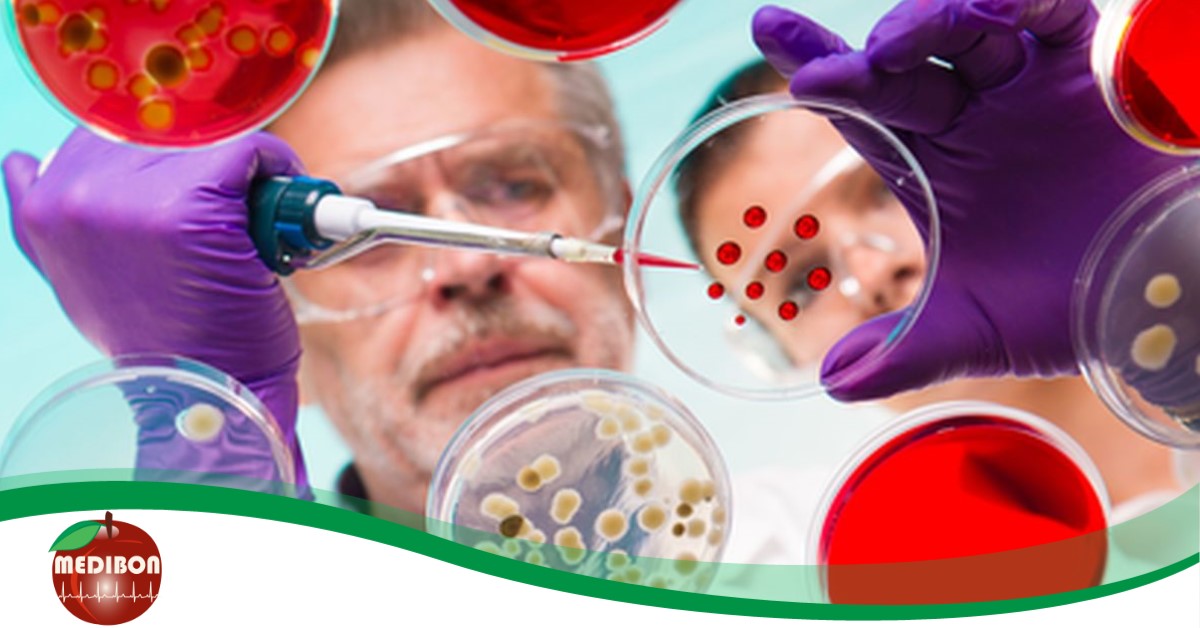
A vérvétel óriási prevenciós értéke, avagy a vérben mindennek nyoma van

A vérvétel óriási prevenciós értéke, avagy a vérben mindennek nyoma van
2019.05.08. 16:00 Dr. Sanih Loai
Mióta felismerték a vér jelentőségét az egészségügyben, azóta elképzelhetetlen a betegségek kiszűrése, diagnosztizálása és gyógyítása a vérkép laboratóriumi elemzése nélkül. Nem véletlenül, hiszen az a folyadék, ami az ereinket élettel tölti meg, mindenről tud, ami a testünkben zajlik. A vérben valóban mindennek nyoma van.
A Medibon csapata is orvoshoz fordult kérdéseivel, méghozzá nem is akárkihez, hanem Dr. Sanih Loai-hoz, a budapesti Orvosdiagnosztika központ vezetőjéhez, laboratóriumi főorvoshoz.
Dr. Sanih rendelőjében már sok-sok éve foglalkoznak vérvétellel, méghozzá prevenciós, azaz betegségmegelőzési szempontok szerint végzik munkájukat. Hitelességüket és szakértelmüket mi sem bizonyítja jobban, mint hogy a Magyarországon forgató külföldi sztárok is az Orvosdiagnosztika főorvosát hívják segítségül, ha baj van.
Medibon: Miben más Önöknél egy vérvétel, mint más klinikákon, SZTK-kon?
Orvosdiagnosztika: Nálunk a páciens és az ő problémája az első. Az a tapasztalatunk, hogy a legtöbb helyen, Magyarországon rugalmatlanul kezelik a páciensek időpontkérését. Sokat kell várniuk, ha nem tudnak elmenni a megadott időpontra, akkor csak későbbre kapnak újat. Vagy, ami a legrosszabb, ha egy betegség sürgősséget igényelne, sokszor, akkor is várni kell a vérvételre, holott a páciensnek pszichésen fontos lenne, hogy túlessen minél hamarabb a vizsgálaton, hogy megnyugodhasson, vagy, ha baj van, akkor tudja, hogy kihez kell fordulnia, hogyan tovább.Mi ebben rugalmasak, és abszolút páciens-központúak vagyunk. Nálunk nincs várakozás, sorban állás, és az eredmények is hamar elkészülnek. A vizsgálat teljességgel megegyezik a standard vérvételi vizsgálatokkal, Dr. Sanih, laborvezető Főorvosként abszolút céltudatosan végzi a munkáját, ahogy a Központunkban mindenki.
Medibon: Mit tudnak kimutatni a vérből? Milyen betegségeket, problémákat?
Orvosdiagnosztika: Bármit, amit hematológiailag meg lehet állapítani egy emberről, azaz szinte mindent. A laboratóriumi vérvizsgálat mindenesetben a betegségek megelőzésének és diagnosztizálásának origója. Ha a szervezetben probléma merül fel, akkor a vérvizsgálat azt igazolja, bizonyítja. A vérben valóban mindennek nyoma van.
Medibon: Milyen szűréseket végeznek?
Orvosdiagnosztika: Vannak adott problémára koncentráló szűréseink is, így van egy nőgyógyászati jellegű, meddőségi szűrésünk, amit szintén a vér szintjén vizsgálunk. Napjainkban a fiatalokat ez a probléma rendkívüli mértékben sújtja, ennek sok oka lehet: a fogamzásgátlás túlzásba vitelétől, a dohányzáson, a helytelen életmódon át, a pszichés terhekig, stresszig stb. Elsődlegesen a meddőség hátterében pszichésen sok esetben a stressz áll, fizikai szinten pedig nagyban közre játszanak a hormonális tényezők, amelyek a vérből kimutathatóak. Nem is gondolnánk, de gyakran sok-sok éves problémát megoldhat egy picike tűszúrás.
Medibon: Tudna példát mondani erre?
Orvosdiagnosztika: Körülbelül 10 éve megkeresett minket egy jól szituált pár, akik már a németországi és a svájci klinikákat is megjárták a problémájukkal. A hölgy 38 éves volt, az úr pedig 45, és még nem volt gyermekük, pedig nagyon régóta próbálkoztak már, és bizony ezzel az életkorral nem számítottak „fiatal gyermekvállalóknak”, ami egészségügyi szempontból csak tovább nehezítette a dolgot. Csináltunk egy alapos vérvizsgálatot, ami ki is mutatta, hol lehet a probléma, a feleség nem sokkal ezután átesett egy kisebb műtéten, és utána jött is az első baba, majd utána, mint az orgonasíp, még három. Ennél nagyobb elismerés nem is kell egy orvosnak, mint azaz öröm és hála, amivel az a pár ajándékozott meg minket!Ha már itt tartunk, a Hölgyeknek 30 éves kor felett legalább félévente érdemes megvizsgáltatniuk a vérképüket, hiszen az élet bizonyos szakaszaiban a női test hormonálisan megbolydul, és nagy változásokon megy keresztül, ami bizonyos esetekben ciszták kialakulását is eredményezheti. Bár a ciszta jóindulatú elváltozás, de maga után vonhat más burjánzásokat, miómát és egyéb problémákat is, amik komolyabb műtéti beavatkozások szükségességét is indokolttá tehetik a későbbiekben.
Medibon: Milyen betegségek előzhetőek meg az időben megvizsgált vérkép jóvoltából?
Orvosdiagnosztika: Hölgyek esetében, ahogy említettem megelőzhetőek a hormonális változások következtében kialakuló nőgyógyászati gondok.Napjainkban sokan panaszkodnak arra, hogy fáj a hátuk, a derekuk, a gyomruk, fáradékonyak… Azonban mielőtt belgyógyászatra, vagy netalán gyomortükrözésre rohannánk a problémánkkal, érdemes csináltatni egy vérképet, mert lehet, nem is ott van a gond, ahol a testünk a fájdalmat jelzi. Ha elkészültünk a vérvizsgálattal, és valamilyen gondot észlelünk a páciensnél, akkor alapos szakmai felkészültségünk révén a megfelelő szakorvoshoz tudjuk őt irányítani a problémájával, így rengeteg időt, várakozást spórolhat meg magának, nem beszélve arról, hogy időben orvosolhatja a bajt. Ilyen esetekben 3 hónapon belül ajánlott kontroll céljából is elmenni vérvételre.
De, hogy konkrét esetről beszéljünk, nem régiben egy sportos, 35 éves fiatalember érkezett hozzánk fáradékonyságra panaszkodva. Többféle vérvizsgálatot is elvégeztünk, az energiahiány okát kutatva, esetében főleg a vércukorszintet vizsgáltuk. Meg is lett a probléma oka: Éhgyomorra 14-es vércukorszintet diagnosztizáltunk az Úrnál, ami komoly cukorbajt jelzett.
Medibon: Az Önök által végzett vérvizsgálat eredményeit mikor kapják meg a páciensek?
Orvosdiagnosztika: Ez problémától függ, de általában 36 órán vagy maximum egy héten belül elkészül. Az egyhetes intervallum, akkor merül fel, ha problémát találunk, mert akkor tovább vizsgáljuk a levett vérmintát.
Medibon: Mik azok a konkrét szűrések, amikkel Önökhöz lehet fordulni?
Orvosdiagnosztika: Alapvetően szűrjük a cukrot, a koleszterint, valamint az úgynevezett tumor-markereket, azaz valamennyi rák faktort a szervezetben, másodlagosan pedig a hormonokat, a pajzsmirigyet vizsgáljuk.
Medibon: Úgy tudjuk, hogy Önöket Magyarországon forgató külföldi sztárok is megkeresték már. Ez igaz?
Orvosdiagnosztika: Igen. Dr. Sanih régebben sokáig mentős orvosként dolgozott, és egyik este felhívták a kórházat, hogy kellene egy olyan orvos, aki franciául vagy angolul beszél. Így történt, hogy Dr. Sanihnak a Fórum Hotelbe kellett mennie aznap este. Amikor belépett a hotelszobába, ahová hívták, a szőnyegen komoly gyomorfájdalmaktól sújtva, G. D., híres francia színész fetrenget. Kapott egy injekciót, majd miután jobban lett, Dr. Sanih mondta neki, hogy a problémája alaposabb vizsgálatot igényel, ezért keresse meg, hogy kezelhesse.Néhány hét múlva, G.D. fel is kereste, és Dr. Sanih páciense lett, olyannyira, hogy még francia orvosával is értekezni kellett az itt készült vizsgálatokról. Ez akkoriban nagy hír volt: „Magyarországon gyógyíttatja magát G.D.”… Ez a hír a filmes berkekben is elterjedt, és számos Magyarországon forgatott produkcióhoz Dr. Saniht hívták stáborvosnak.
Cikkünkből kiderült, hogy mit tehet egy vérvizsgálat értünk, és milyen prevenciós értékkel bír, ha időben megnézettjük a vérképünket. A szervezetünk minden problémát jelez, de rohanó mindennapjainkban nem „halljuk meg”. Pedig rengeteget számít, ha időben orvosoljuk a bajokat!
Dr. Sanih és csapata az Orvosdiagnosztika Központban elsősorban a prevencióra törekszenek. Ezt nem lehet elégszer ismételni, mert sajnos az emberek többsége, még mindig csak akkor fordul orvoshoz, ha már kialakult a baj. Pedig az orvos nem Isten… Van, amikor már nem lehet segíteni. A megelőzés ezért is olyan égetően fontos, mert emberléptékű lehetőség arra, hogy sokáig egészségesek lehessünk.
Ha érdekelnek a kedvezményes egészségügyi ajánlataink, kattints IDE, és görgess lefelé.






